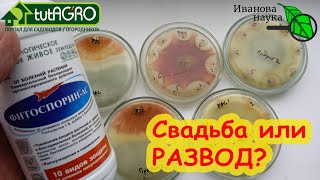

МОРКОВЬ ПО КОРЕЙСКИ С ПАПОРОТНИКОМ
Морковь по корейски с папоротником - восхитительное блюдо из корейской кухни, объединяющее в себе сочные морковные ломтики и ароматный папоротник. Это уникальное сочетание придает блюду особый вкус и текстуру.
Готовить морковь по корейски с папоротником довольно просто. Сначала морковь нарезают тонкими ломтиками, затем она маринуется в соусе, состоящем из соевого соуса, сахара, чеснока, перца и растительного масла. Папоротник, в свою очередь, обрабатывается, чтобы устранить горечь и приторность. После этого он добавляется к моркови и все смешивается, чтобы ингредиенты хорошо пропитались.
Морковь по корейски с папоротником прекрасно сочетается с основными блюдами, такими как рис или мясные гарниры, а также может выступать в качестве самостоятельного закусочного блюда. Это яркое и аппетитное блюдо порадует гурманов и ценителей корейской кухни.
Попробуйте приготовить морковь по корейски с папоротником и насладитесь его неповторимым вкусом и ароматом. Уверены, что этот рецепт станет отличным дополнением к вашему столу и понравится всем любителям восточной кухни!
Рецепт салата из папоротника МИНАРИ ЧА. Очень вкусно получается!
ПАПОРОТНИК по - Корейски.Как ГРИБЫ. Самый вкусный салат.Косари ча.
Королевский Салат на Новый 2024 Год! Вкусный, Яркий, Красивый!
РЕЦЕПТ КАК У КОРЕЙЦЕВ НА РЫНКЕ, УЗНАЛА ВСЕ СЕКРЕТЫ! МОРКОВЬ ПО-КОРЕЙСКИ, КОРЕЙСКАЯ МОРКОВЬ.
Куриные желудки по-корейски. Вкуснотища необыкновенная!
Вырастить МОРКОВЬ как дважды два!
Очень вкусный салат из папоротника.